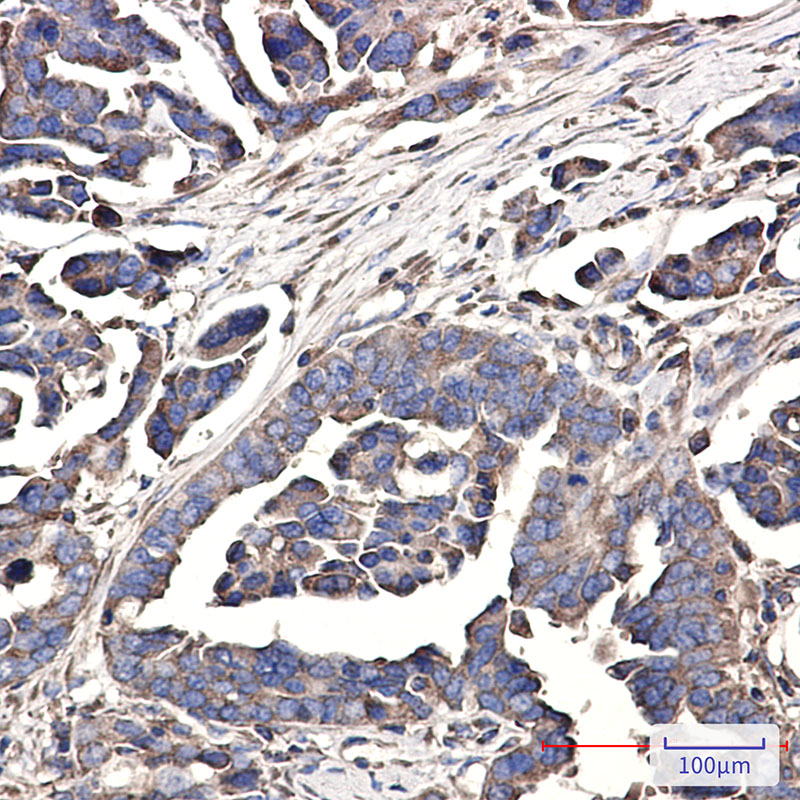

-
分类: 科研抗体货号: P22151别名: Serine/threonine-protein kinase ULK3; Ulk3; unc 51 like kinase 3 (C. elegans); Unc-51-like kinase 3应用: WB反应种属: Human
-
分类: 科研抗体货号: P22176别名: WNT16; Protein Wnt-16应用: WB,IP反应种属: Human,Mouse,Rat
-
分类: 科研抗体货号: P22165别名: TAP; VDP; P115应用: WB,IP反应种属: Mouse
-
分类: 科研抗体货号: P22175别名: WDR5; BIG3; WD repeat-containing protein 5; BMP2-induced 3-kb gene protein应用: WB反应种属: Human,Mouse,Rat
-
分类: 科研抗体货号: P22180别名: API3; ILP1; MIHA; XLP2; BIRC4; IAP-3; hIAP3; hIAP-3应用: WB反应种属: Human,Mouse,Rat
-
分类: 科研抗体货号: P22163别名: VEGFA; VEGF; Vascular endothelial growth factor A; VEGF-A; Vascular permeability factor; VPF应用: WB反应种属: Human,Mouse,Rat
-
分类: 科研抗体货号: P22174别名: AIP1; NORI-1; HEL-S-52应用: WB,IHC,IF反应种属: Human
-
分类: 科研抗体货号: P22179别名: Xanthine dehydrogenase; Xanthine oxidase; Xanthine oxidoreductase; XD; XDH; xdha; XO; xor应用: WB反应种属: Human
-
分类: 科研抗体货号: P22190别名: ZAP70; SRK; Tyrosine-protein kinase ZAP-70; 70 kDa zeta-chain associated protein; Syk-related tyrosine kinase应用: WB,IP反应种属: Human,Mouse,Rat
-
分类: 科研抗体货号: P22173别名: WAVE; SCAR1; WAVE1应用: WB反应种属: Human,Mouse,Rat

鄂公网安备42018502007531号
鄂公网安备42018502007531号

